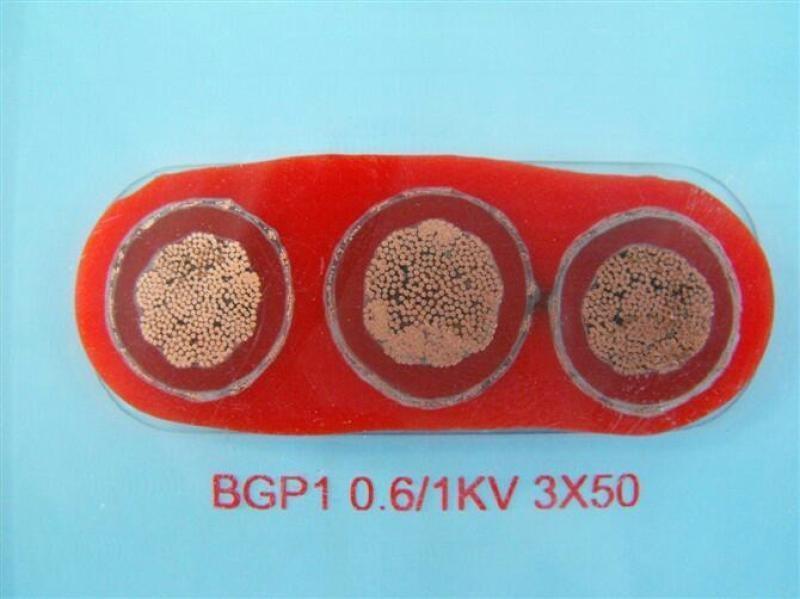

商铺名称:安徽天缆电气有限公司
联系人:郭中清(先生)
联系手机:
固定电话:
企业邮箱:zgtzdl@163.com
联系地址:安徽省天长市永丰工业园区2号
邮编:239300
联系我时,请说是在万物包装网上看到的,谢谢!
YVFQB扁电缆/YVFB扁电缆/YVFB,YVFBG行车扁电缆/安徽天缆电气有限公司供应

YVFQB扁电缆适用于交流额定电压0.6/1KV及以下固定敷设用动力传输线或移动电器用连接电缆。
产品具有耐热辐射、耐寒、耐酸碱及腐蚀性气体、防水等特性,电缆结构柔软,辐射方便,
高温(高寒)环境下电气性能稳定,舒缓老化性能突出,使用寿命长。
广泛用于冶金、电力、石化、电子、汽车制造等行业。
●安徽天缆电气有限公司技术参数:
工作电压:450/750V 0.6/1KV
测试电缆:2500V 3500V
导体电阻20℃ :根据VDE 0295及IEC 60228第5类,多股细绞铜丝
绝缘电阻:≥ 20 MΩ/km (20℃)
弯曲半径:
固定安装 8 X D(电缆外径)
移动安装 10 X D(电缆外径)
工作温度:
固定安装 - 40 ~ 70℃
移动安装 - 30 ~ 70℃
皖特缆注意事项:
安装使用前应自由垂吊,充分退扭(避免出现线缆打结和波浪扭曲);
钢绳加强芯剥离后应进行固定,同时应承受线缆自身重量及运行拉力;
两条钢绳加强芯剥离后应保持对称一致拉力,其所受拉力与平均值偏差应小于5%;
电梯轿厢压缩电梯缓冲器时,电梯专用视频线不得与底坑和轿厢底边框接触;
安装时线缆视频、电源接口不得有虚焊、脱焊且应固定牢实。
●安徽天缆电气有限公司线缆结构
导 线: : 裸铜多股线, 符合 IEC 60228EN 60228, VDE 0295, 5 级
绝 缘: PVC
颜 色 代 码: : 符合颜色代码 HD308(VDE0293 第308部分);
自6根芯线起带有连续编号的黑色芯线
符合EN 50334;
自3根芯线起带一根黄绿接地线
芯 线 结 构: 芯线平行并列排列
护 层 材 料: PVC
护 套 颜 色: : 黑色 (RAL 9005)
安徽天缆电气有限公司生产的拖拽电缆、拖令电缆、抗拉耐磨电缆、聚氨酯(PUR/TPU)电缆、防海水电缆、零浮力电缆、
漂浮电缆、水下电缆,吊篮电缆,吊具电缆,斗轮机**电缆,电动铲运机电缆,卸船机电缆,抓吊电缆,堆取料机卷盘
电缆广泛应用于化工、消防、冶金、电力等基础性必选的产业,与现代化的工程理念相配套。
安徽天缆电气有限公司生产的电缆广泛应用于化工、消防、冶金、电力等基础性必选的产业,与现代化的工程理念相配套。



















